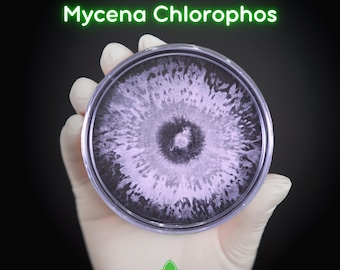
Green Pepe (Mycena Chlorophos) Live Mycelium Mushroom Culture Spawn
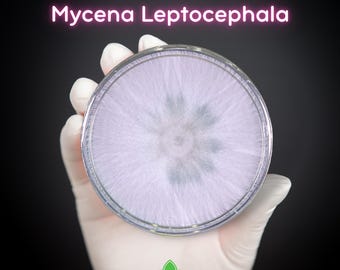
Nitrous Bonnet (Mycena Leptocephala) Live Mycelium Mushroom Culture Spawn

Price:₪94.30
Luminescence Mycena chlorophos glowing fungus Live culture Live mycelia on agar / liquid culture from Japan
Star Seller
Star Sellers have an outstanding track record for providing a great customer experience—they consistently earned 5-star reviews, shipped orders on time, and replied quickly to any messages they received.
Returns & exchanges accepted
You can only make an offer when buying a single item
Star Seller. This seller consistently earned 5-star reviews, shipped on time, and replied quickly to any messages they received.
Buy together, get 15% off
 This listing
This listing
Luminescence Mycena chlorophos glowing fungus Live culture Live mycelia on agar / liquid culture from Japan
Sale Price ₪80.16
Original Price ₪94.30
Original value: ₪169.74
New total: ₪144.28
Pure live mycelia of Mycena Chlorophos on Agar (small test tube, 12*75 mm) or in liquid culture (syringe, 4 ml). It's not mushroom, it's mycelium.
Native to Japan
Attention: Basic knowledge of microbiology is NEEDED! (Aseptic techniques & substrate sterilization). Mycena Chlorophos is not friendly to beginners. If you don't have experience with mushroom cultivation, only order after serious consideration.
Important: This mushroom is inedible. Its main attraction is that it glows in the dark.
You will also receive an introduction about how to grow it.
Mycena Chlorophos is not recommended for beginners because 1). The bioluminescence of mycelium cannot be detected by the naked eye (only the fruitbody glows for about 1 week) 2). Fruiting needs critical conditions (certain temperature, light, and aeration) 3). Casing layer is necessary for the fruit body formation
Important: The inoculation and cultivation of fungi need basic knowledge of microbiology.
🌱 Want to Grow Your Own?
If you don’t have microbiology experience, try our beginner-friendly Panellus stipticus and Mycena chlorophos Ready-to-Use Grow Kit:
✔️ Pre-sterilized containers & substrates (no autoclaves or boiling needed)
✔️Simple, ready-to-use – No mushroom cultivation experience needed
✔️ Designed for easy success and fast results
You are always welcome to ask any question at any time :-)
-
Ships out within 1–3 business days
-
Returns & exchanges accepted within 30 days
Buyers are responsible for return shipping costs. If the item is not returned in its original condition, the buyer is responsible for any loss in value.
-
Ships from: Germany
Sorry, this item doesn’t ship to Israel. Contact the shop to find out about available shipping options.
There was a problem calculating your shipping. Please try again.
Etsy Purchase Protection
Shop confidently on Etsy knowing if something goes wrong with an order, we've got your back for all eligible purchases —
see program terms
Reviews for this item (18)
I tested the culture, it works on multiple petri dishes. It also comes with a very good description by the seller on how to cultivate them. Highly recommended
The seller responds kindly to your messages the plates are high quality good~
What a marvellous and special shop. Wonderful stuff. Good communication, very helpful feedback after questions. Fast. Some of my orders were easy to get busy with, other were difficult, but the shop helped me through everything. A shop I will visit again and place orders. And we’re very stoked to see the result of the cultures we bought. The perfect thing to start 2023 with. This will be continued! Jeffrey & Wendy
Just Perfect!
All reviews are from verified buyers. Reviews are shown automatically based on factors like recency, whether they include comments, your chosen language, and whether the rating reflects the typical experience with the shop.
Photos from reviews
More from this shop
Visit shop-

Spare parts set for the glow mushroom Panellus Stipticus
₪75.44
-

Glowing mushroom luminescence Panellus stipticus in the bottle "living mushroom"
₪120.70
-

Glowing Mushroom Luminescence Panellus stipticus "Ready to use Grow-Up Kit" Luminescent Mushroom
₪120.70
-

Luminescence Panellus stipticus glowing mushroom in the bottle "live mushroom" + spare parts set
₪147.11
-
Green Pepe (Mycena Chlorophos) Live Mycelium Mushroom Culture Spawn
₪165.35
-

Glow in the Dark | Bioluminescent Mushroom Liquid Culture of the Green Pepe / Yakoh-Take (Mycena chlorophos)
₪75.44
-

Ghost Fungus (Omphalotus Nidiformis) Live Mycelium Mushroom Culture Spawn
₪106.89
-

Night Fire (Mycena Noctilucens) Live Mycelium Mushroom Culture Spawn Seed
₪240.50
-

Bleeding Bonnet (Mycena Aff Sanguinolenta) Live Mycelium Mushroom Culture Spawn
₪215.45
-
Nitrous Bonnet (Mycena Leptocephala) Live Mycelium Mushroom Culture Spawn
₪106.89















































